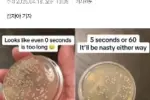

이미지 텍스트 확인
뒤에 보이는 민둥산
사신
선
세중대왕의 모습
@중국
‘맞이하는 우리의 성군 세중대왕님올 보자:
중국 사신올
사신이 당도하자 임금중은 ..여러 신하와 더불어 비
*중국
절하고 악차로 들어가 면복올 입고 나와 네 번 절하고 창
피우며, 또 네 번 절하고 만세률 부르미 총추고 발구르다 벼년
절하고 [세종1(1419)-1-19]
실륙에는 세종이 중국 사신 앞에서 춤추고 발구르고 절하는 모습
이 나용다 근절만 총16번 하느데 다른 이씨 왕도 다 그리하다
더 자세한 이야기는 ‘일성록’ 에 나온다.
또 한명의 대왕 영조의 중국사신 영접현장.
*상께서네 번 절들 하시고 .. 끓어앉으섞다.
부딪
엷다가 일어서방다.직서가 있다고 하자
흔적 그리고
영은문의
독립문과
앞에
상께서
끓어앉이|
상께서
추시고 끓어앉아 세 번
이미지 텍스트 확인
CI:
것율 창하자 끓어앉앉다 j
0″”
세 번 이마을
#번 @올
세 번 이마을
잔례가 계
#번
맞잡아 이마에 없고서 ‘만세’ 라고
하여다.
‘만세’ 라고 하여다 .
‘만만세’ 라고 하여다.
재차
상체틀 일으켜 네 번절활 것올 계청하자 ,
하시고.
재배레릇 행하시고 [영조3g11763)-8-4]
‘
끼 드라마예서는 청국 사신이 조선 왕에게 절하는 것으로 나오
지만 실제는 정반대다 . 왕이 중국 사신에계 근절하고 춤 추고 발
구르고 ” 조통 수준의 예법올 중국에 서 장난처럼 만들어 즐겪다 .
청나라예 정복 당해서 절하고 조아린 것을 ‘삼전도의 치욕’ 이라
거 네 번
고 향울
말하는데, 그 치옥은 명나라 아니 다른 놈에게 절하게 된 데 대
겨 네 번
현 분노없고, 조선은 그런 치욕 좀 밥먹듯이 당하면 나라다.
‘세 번 충울
이마률
조아리섯
‘상꺼서
끓어앉올
찬의가
창하자
감의가 .
끓어앉아
조아리벗다 .. 그대로
추고
끓어앉아
조아리섯다.
추고
충율
손물
상께서
천히자
계청하자 ,
다시
켜가
계청하자 ,
현금가
부복하얹다가
얼폐가
그대로
상께서
중국 사신이 당도하자 임금은 세하(# )틀 하고 여러 신하
이미지 텍스트 확인
와 더불어 비틀 절하여 악차로 들어간다:
복울 입고 나오면 네 번 절하고 향울 피우미 또 네 번 절하
고 만세름 부르다:
이어 춤추고 발올 구르려 다시 네 번 절하다
[세종 1년(1419) 1월 19일]
1. 세하(#쪽): 임금이 손님(사신)올 맞이할 때 예틀 갖추어
인사하는 절차:
2 여러 신하와 함께 절하고 악차(뜻X 의레용 악기 약대)로
들어감 신하들과 함께 사신올 맞아 절하고 음악이 울리는
가운데 예법대로 자리름 들어감

이미지 텍스트 확인
사극 속에 절대 안 나오는 댄싱킹 세종 ㄷㄷㄷㄷ
춤도 잘추네요 ㄷㄷㄷㄷㄷㄷㄷㄷ